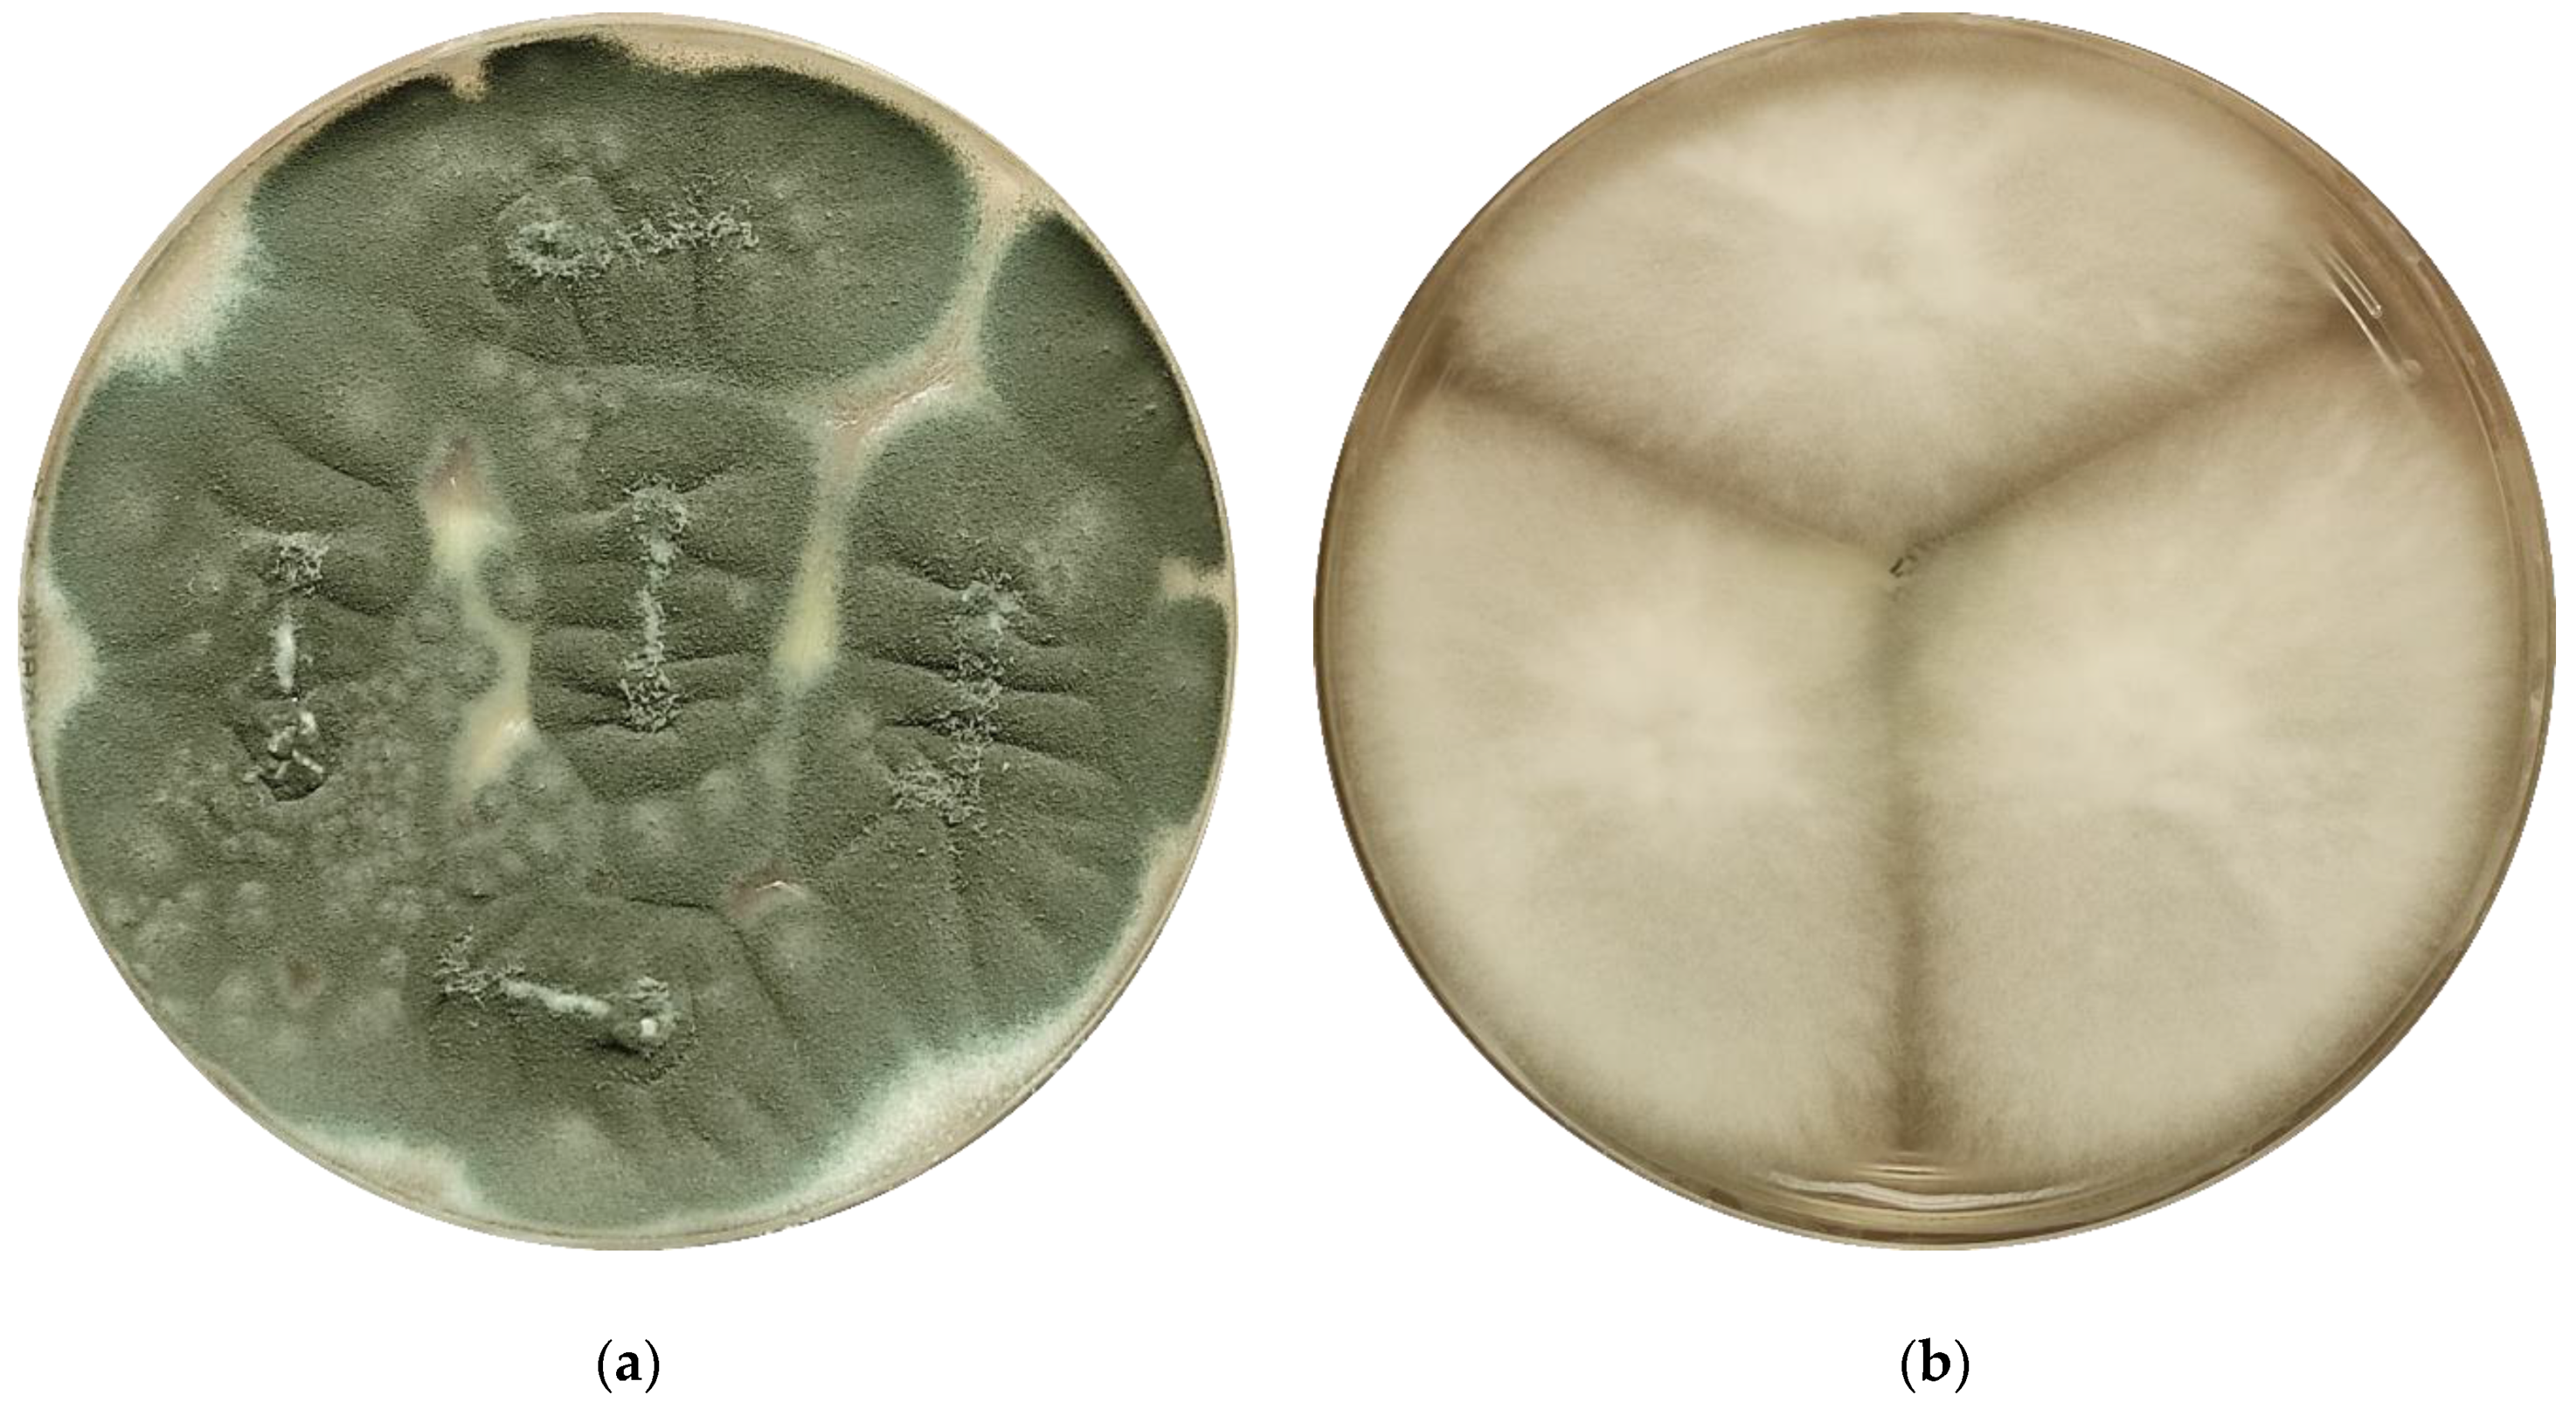

Updated EUCAST Clinical Breakpoints against Aspergillus, Implications for the Clinical Microbiology Laboratory
Abstract
1. Introduction
2. Epidemiology and Patterns of Antifungal Susceptibility of Species Causing Aspergillosis
3. Clinical Impact of Azole Resistance in the Management of Patients with Invasive Aspergillosis
4. The EUCAST Subcommittee on Antifungal Susceptibility Testing—Methods for the Detection of Azole Resistance in Aspergillus spp. Isolates
5. Changes in EUCAST Antifungal Clinical Breakpoints against Aspergillus spp. (2020 Update)
6. Conclusions
Funding
Acknowledgments
Conflicts of Interest
References
- Kosmidis, C.; Denning, D.W. The clinical spectrum of pulmonary aspergillosis. Thorax 2014, 70, 270–277. [Google Scholar] [CrossRef]
- Lestrade, P.P.; Van Der Velden, W.J.F.M.; Bouwman, F.; Stoop, F.J.; Blijlevens, N.M.A.; Melchers, W.J.G.; Verweij, P.E.; Donnelly, J.P. Epidemiology of invasive aspergillosis and triazole-resistant Aspergillus fumigatus in patients with haematological malignancies: A single-centre retrospective cohort study. J. Antimicrob. Chemother. 2018, 73, 1389–1394. [Google Scholar] [CrossRef]
- Peri, A.; Bisi, L.; Cappelletti, A.; Colella, E.; Verga, L.; Borella, C.; Foresti, S.; Migliorino, G.; Gori, A.; Bandera, A. Invasive aspergillosis with pulmonary and central nervous system involvement during ibrutinib therapy for relapsed chronic lymphocytic leukaemia: Case report. Clin. Microbiol. Infect. 2018, 24, 785–786. [Google Scholar] [CrossRef] [PubMed]
- Wanner, A.; Schmid, A. Faculty Opinions recommendation of Pulmonary aspergillosis in patients with chronic obstructive pulmonary disease: Incidence, risk factors, and outcome. Fac. Opin. Post Publ. Peer Rev. Biomed. Lit. 2011, 16, 870–877. [Google Scholar] [CrossRef]
- Verweij, P.E.; Brüggemann, R.J.M.; Wauters, J.; Rijnders, B.J.A.; Chiller, T.; Van De Veerdonk, F.L. Influenza Coinfection: Be(a)ware of Invasive Aspergillosis. Clin. Infect. Dis. 2020, 70, 349–350. [Google Scholar] [CrossRef] [PubMed]
- Helleberg, M.; Steensen, M.; Arendrup, M.C. Invasive aspergillosis in patients with severe COVID-19 pneumonia. Clin. Microbiol. Infect. 2020. [Google Scholar] [CrossRef] [PubMed]
- Ullmann, A.; Aguado, J.; Arikan-Akdagli, S.; Denning, D.; Groll, A.; Lagrou, K.; Lass-Flörl, C.; Lewis, R.; Munoz, P.; Verweij, P.; et al. Diagnosis and management of Aspergillus diseases: Executive summary of the 2017 ESCMID-ECMM-ERS guideline. Clin. Microbiol. Infect. 2018, 24, e1–e38. [Google Scholar] [CrossRef]
- Patterson, T.F.; Thompson, G.R.; Denning, D.W.; Fishman, J.A.; Hadley, S.; Herbrecht, R.; Kontoyiannis, D.P.; Marr, K.A.; Morrison, V.A.; Nguyen, M.H.; et al. Executive Summary: Practice Guidelines for the Diagnosis and Management of Aspergillosis: 2016 Update by the Infectious Diseases Society of America. Clin. Infect. Dis. 2016, 63, 433–442. [Google Scholar] [CrossRef]
- Alastruey-Izquierdo, A.; Alcazar-Fuoli, L.; Cuenca-Estrella, M. Antifungal Susceptibility Profile of Cryptic Species of Aspergillus. Mycopathologia 2014, 178, 427–433. [Google Scholar] [CrossRef]
- Houbraken, J.; Kocsubé, S.; Visagie, C.M.; Yilmaz, N.; Wang, X.-C.; Meijer, M.; Kraak, B.; Hubka, V.; Bensch, K.; Samson, R.; et al. Classification of Aspergillus, Penicillium, Talaromyces and related genera (Eurotiales): An overview of families, genera, subgenera, sections, series and species. Stud. Mycol. 2020, 95, 5–169. [Google Scholar] [CrossRef]
- Alastruey-Izquierdo, A.; Mellado, E.; Peláez, T.; Pemán, J.; Zapico, S.; Alvarez, M.; Rodríguez-Tudela, J.L.; Cuenca-Estrella, M.; FILPOP Study Group. Population-Based Survey of Filamentous Fungi and Antifungal Resistance in Spain (FILPOP Study). Antimicrob. Agents Chemother. 2013, 57, 3380–3387. [Google Scholar] [CrossRef] [PubMed]
- Alastruey-Izquierdo, A.; Alcazar-Fuoli, L.; Rivero-Menendez, O.; Ayats, J.; Castro, C.; García-Rodríguez, J.; Goterris-Bonet, L.; Ibáñez-Martínez, E.; Linares-Sicilia, M.J.; Martin-Gomez, M.T.; et al. Molecular Identification and Susceptibility Testing of Molds Isolated in a Prospective Surveillance of Triazole Resistance in Spain (FILPOP2 Study). Antimicrob. Agents Chemother. 2018, 62, 00358-18. [Google Scholar] [CrossRef] [PubMed]
- Escribano, P.; Rodríguez-Sánchez, B.; Díaz-García, J.; Martín-Gómez, M.T.; Ibáñez-Martínez, E.; Rodríguez-Mayo, M.; Peláez, T.; De La Pedrosa, E.G.-G.; Tejero-García, R.; Marimón, J.M.; et al. Azole resistance survey on clinical Aspergillus fumigatus isolates in Spain. Clin. Microbiol. Infect. 2020, in press. [Google Scholar] [CrossRef] [PubMed]
- Perlin, D.S.; Rautemaa-Richardson, R.; Alastruey-Izquierdo, A. The global problem of antifungal resistance: Prevalence, mechanisms, and management. Lancet Infect. Dis. 2017, 17, e383–e392. [Google Scholar] [CrossRef]
- Van Der Linden, J.W.; Warris, A.; Verweij, P.E. Aspergillus species intrinsically resistant to antifungal agents. Med. Mycol. 2011, 49 (Suppl. 1), S82–S89. [Google Scholar] [CrossRef]
- Anderson, J.B. Evolution of antifungal-drug resistance: Mechanisms and pathogen fitness. Nat. Rev. Genet. 2005, 3, 547–556. [Google Scholar] [CrossRef]
- Van Der Linden, J.; Arendrup, M.; Warris, A.; Lagrou, K.; Pelloux, H.; Hauser, P.; Chryssanthou, E.; Mellado, E.; Kidd, S.; Tortorano, A.; et al. Prospective Multicenter International Surveillance of Azole Resistance in Aspergillus fumigatus. Emerg. Infect. Dis. 2015, 21, 1041–1044. [Google Scholar] [CrossRef]
- Verweij, P.E.; Chowdhary, A.; Melchers, W.J.; Meis, J.F. Azole Resistance in Aspergillus fumigatus: Can We Retain the Clinical Use of Mold-Active Antifungal Azoles? Clin. Infect. Dis. 2016, 62, 362–368. [Google Scholar] [CrossRef]
- Lestrade, P.P.; Meis, J.F.; Melchers, W.J.; Verweij, P.E. Triazole resistance in Aspergillus fumigatus: Recent insights and challenges for patient management. Clin. Microbiol. Infect. 2019, 25, 799–806. [Google Scholar] [CrossRef]
- Rivero-Menendez, O.; Alastruey-Izquierdo, A.; Mellado, E.; Cuenca-Estrella, M. Triazole Resistance in Aspergillus spp.: A Worldwide Problem? J. Fungi 2016, 2, 21. [Google Scholar] [CrossRef]
- Garcia-Rubio, R.; Cuenca-Estrella, M.; Mellado, E. Triazole Resistance in Aspergillus Species: An Emerging Problem. Drugs 2017, 77, 599–613. [Google Scholar] [CrossRef] [PubMed]
- Pérez-Cantero, A.; López-Fernández, L.; Guarro-Artigas, J.; Capilla, J. Azole resistance mechanisms in Aspergillus: Update and recent advances. Int. J. Antimicrob. Agents 2020, 55, 105807. [Google Scholar] [CrossRef] [PubMed]
- Hendrickson, J.A.; Hu, C.; Aitken, S.L.; Beyda, N. Antifungal Resistance: A Concerning Trend for the Present and Future. Curr. Infect. Dis. Rep. 2019, 21, 47. [Google Scholar] [CrossRef] [PubMed]
- Van Der Linden, J.W.M.; Snelders, E.; Kampinga, G.A.; Rijnders, B.J.A.; Mattsson, E.; Debets-Ossenkopp, Y.J.; Kuijper, E.J.; Van Tiel, F.H.; Melchers, W.J.G.; Verweij, P.E. Clinical Implications of Azole Resistance in Aspergillus fumigatus, the Netherlands, 2007–2009. Emerg. Infect. Dis. 2011, 17, 1846–1854. [Google Scholar] [CrossRef] [PubMed]
- Chong, G.M.; van der Beek, M.T.; Von dem Borne, P.A.; Boelens, J.; Steel, E.; Kampinga, G.A.; Span, L.F.R.; Lagrou, K.; Maertens, J.A.; Dingemans, G.J.; et al. PCR-based detection of Aspergillus fumigatus Cyp51A mutations on bronchoalveolar lavage: A multicentre validation of the AsperGenius assay® in 201 patients with haematological disease suspected for invasive aspergillosis. J. Antimicrob. Chemother. 2016, 71, 3528–3535. [Google Scholar] [CrossRef] [PubMed]
- Lestrade, P.P.; Bentvelsen, R.G.; Schauwvlieghe, A.F.A.D.; Schalekamp, S.; Van Der Velden, W.J.F.M.; Kuiper, E.J.; Van Paassen, J.; Van Der Hoven, B.; Van Der Lee, H.A.; Melchers, W.J.G.; et al. Voriconazole Resistance and Mortality in Invasive Aspergillosis: A Multicenter Retrospective Cohort Study. Clin. Infect. Dis. 2019, 68, 1463–1471. [Google Scholar] [CrossRef]
- Verweij, P.E.; Ananda-Rajah, M.; Andes, D.; Arendrup, M.C.; Brüggemann, R.J.; Chowdhary, A.; Cornely, O.A.; Denning, D.W.; Groll, A.H.; Izumikawa, K.; et al. International expert opinion on the management of infection caused by azole-resistant Aspergillus fumigatus. Drug Resist. Updat. 2015, 21–22, 30–40. [Google Scholar] [CrossRef]
- European Committee on Antimicrobial Susceptibility Testing, Antifungal Susceptibility Testing. Available online: https://www.eucast.org/ast_of_fungi/ (accessed on 4 December 2020).
- Guinea, J.; Verweij, P.; Meletiadis, J.; Mouton, J.W.; Barchiesi, F.; Arendrup, M.C.; Arikan-Akdagli, S.; Castanheira, M.; Chryssanthou, E.; Friberg, N.; et al. How to: EUCAST recommendations on the screening procedure E.Def 10.1 for the detection of azole resistance in Aspergillus fumigatus isolates using four-well azole-containing agar plates. Clin. Microbiol. Infect. 2019, 25, 681–687. [Google Scholar] [CrossRef]
- Arendrup, M.; Hope, W.; Howard, S. EUCAST Definitive Document E.Def 9.2 Method for the Determination of Broth Dilution Minimum Inhibitory Concentrations of Antifungal Agents for Conidia Forming Moulds. Available online: https://www.eucast.org/ast_of_fungi/ (accessed on 4 December 2020).
- The European Committee on Antimicrobial Susceptibility Testing. Routine and Extended Internal Quality Control for MIC Determination and Agar Dilution for Yeasts, Moulds and Dermatophytes as Recommended by EUCAST. Version 5.0. 2020. Available online: https://www.eucast.org/ast_of_fungi/ (accessed on 4 December 2020).
- Serrano-Lobo, J.; Gómez, A.; Sánchez-Yebra, W.; Fajardo, M.; Lorenzo, B.; Sánchez-Reus, F.; Vidal, I.; Fernández-Torres, M.; Sánchez-Romero, I.; De Alegría-Puig, C.R.; et al. Azole and amphotericin B minimum inhibitory concentrations against Aspergillus fumigatus: High agreement between spectrophotometric and visual readings using the EUCAST 9.3.2 procedure. Antimicrob. Agents Chemother. 2020, 65, 01693-20. [Google Scholar] [CrossRef]
- Arendrup, M.C.; Friberg, N.; Mares, M.; Kahlmeter, G.; Meletiadis, J.; Guinea, J.; Andersen, C.; Arikan-Akdagli, S.; Barchiesi, F.; Chryssanthou, E.; et al. How to interpret MICs of antifungal compounds according to the revised clinical breakpoints v. 10.0 European committee on antimicrobial susceptibility testing (EUCAST). Clin. Microbiol. Infect. 2020, 26, 1464–1472. [Google Scholar] [CrossRef]
- Rivero-Menendez, O.; Soto-Debran, J.C.; Medina, N.; Lucio, J.; Mellado, E.; Alastruey-Izquierdo, A. Molecular Identification, Antifungal Susceptibility Testing, and Mechanisms of Azole Resistance in Aspergillus Species Received within a Surveillance Program on Antifungal Resistance in Spain. Antimicrob. Agents Chemother. 2019, 63, 00865-19. [Google Scholar] [CrossRef] [PubMed]
- Jørgensen, K.M.; Guinea, J.; Meletiadis, J.; Hare, R.K.; Arendrup, M.C. Revision of EUCAST breakpoints: Consequences for susceptibility of contemporary Danish mould isolates to isavuconazole and comparators. J. Antimicrob. Chemother. 2020, 75, 2573–2581. [Google Scholar] [CrossRef] [PubMed]

| Amphotericin B (mg/L) | |||
|---|---|---|---|
| WT (ECOFF) ≤ | S ≤ | R > | |
| A. flavus | 4 | - | - |
| A. fumigatus | 1 | 1 | 1 |
| A. nidulans | 4 | - | - |
| A. niger | 0.5 | 1 | 1 |
| A. terreus | 8 | - | - |
| Itraconazole (mg/L) | Posaconazole (mg/L) | |||||||
|---|---|---|---|---|---|---|---|---|
| WT (ECOFF) ≤ | S ≤ | R > | ATU | WT (ECOFF) ≤ | S ≤ | R > | ATU | |
| A. flavus | 1 | 1 | 1 | 2 | 0.5 | ND | ND | ND |
| A. fumigatus | 1 | 1 | 1 | 2 | 0.25 | 0.125 | 0.25 | 0.25 |
| A. nidulans | 1 | 1 | 1 | 2 | 0.5 | ND | ND | ND |
| A. niger | 4 | ND | ND | ND | 0.5 | ND | ND | ND |
| A. terreus | 0.5 | 1 | 1 | 2 | 0.25 | 0.125 | 0.25 | 0.25 |
| Voriconazole (mg/L) | Isavuconazole (mg/L) | |||||||
|---|---|---|---|---|---|---|---|---|
| WT (ECOFF) ≤ | S ≤ | R > | ATU | WT (ECOFF) ≤ | S ≤ | R > | ATU | |
| A. flavus | 2 | ND | ND | ND | 2 | 1 | 2 | 2 |
| A. fumigatus | 1 | 1 | 1 | 2 | 2 | 1 | 2 | 2 |
| A. nidulans | 1 | 1 | 1 | 2 | 0.25 | 0.25 | 0.25 | ND |
| A. niger | 2 | ND | ND | ND | 4 | ND | ND | ND |
| A. terreus | 2 | ND | ND | ND | 1 | 1 | 2 | ND |
Publisher’s Note: MDPI stays neutral with regard to jurisdictional claims in published maps and institutional affiliations. |
© 2020 by the author. Licensee MDPI, Basel, Switzerland. This article is an open access article distributed under the terms and conditions of the Creative Commons Attribution (CC BY) license (http://creativecommons.org/licenses/by/4.0/).
Share and Cite
Guinea, J. Updated EUCAST Clinical Breakpoints against Aspergillus, Implications for the Clinical Microbiology Laboratory. J. Fungi 2020, 6, 343. https://doi.org/10.3390/jof6040343
Guinea J. Updated EUCAST Clinical Breakpoints against Aspergillus, Implications for the Clinical Microbiology Laboratory. Journal of Fungi. 2020; 6(4):343. https://doi.org/10.3390/jof6040343
Chicago/Turabian StyleGuinea, Jesús. 2020. "Updated EUCAST Clinical Breakpoints against Aspergillus, Implications for the Clinical Microbiology Laboratory" Journal of Fungi 6, no. 4: 343. https://doi.org/10.3390/jof6040343
APA StyleGuinea, J. (2020). Updated EUCAST Clinical Breakpoints against Aspergillus, Implications for the Clinical Microbiology Laboratory. Journal of Fungi, 6(4), 343. https://doi.org/10.3390/jof6040343
